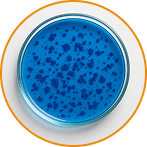

Acelera os resultados da fototerapia com ação regeneradora profunda.

Reforça a barreira cutânea e promove renovação celular com conforto e segurança.

Desenvolvido especialmente para atuar com laser vermelho (612nm), potencializando o efeito clínico da luz. Pode-se usar o led vermelho.

Resultados visíveis que fidelizam seus clientes e aumentam o valor percebido do seu atendimento.

Tecnologia patenteada e registro na ANVISA garantem segurança e inovação no uso clínico.

Rica em ômegas e vitaminas, restaura a maciez e melhora o viço da pele.

Purificante e protetor, fortalece a barreira cutânea.

Hidratação profunda e ação antioxidante contra o estresse ambiental.
Agente fotossensibilizador que potencializa a ação da luz vermelha (612nm).
Em Até 4x sem Juros
Pagando no Pix!
Produto Registrado e Aprovado pela Anvisa
Ainda tem alguma dúvida? Entre em contato com a nossa equipe no WhatsApp pelo Botão Abaixo!
Entre ou cadastre-se para ver suas compras.